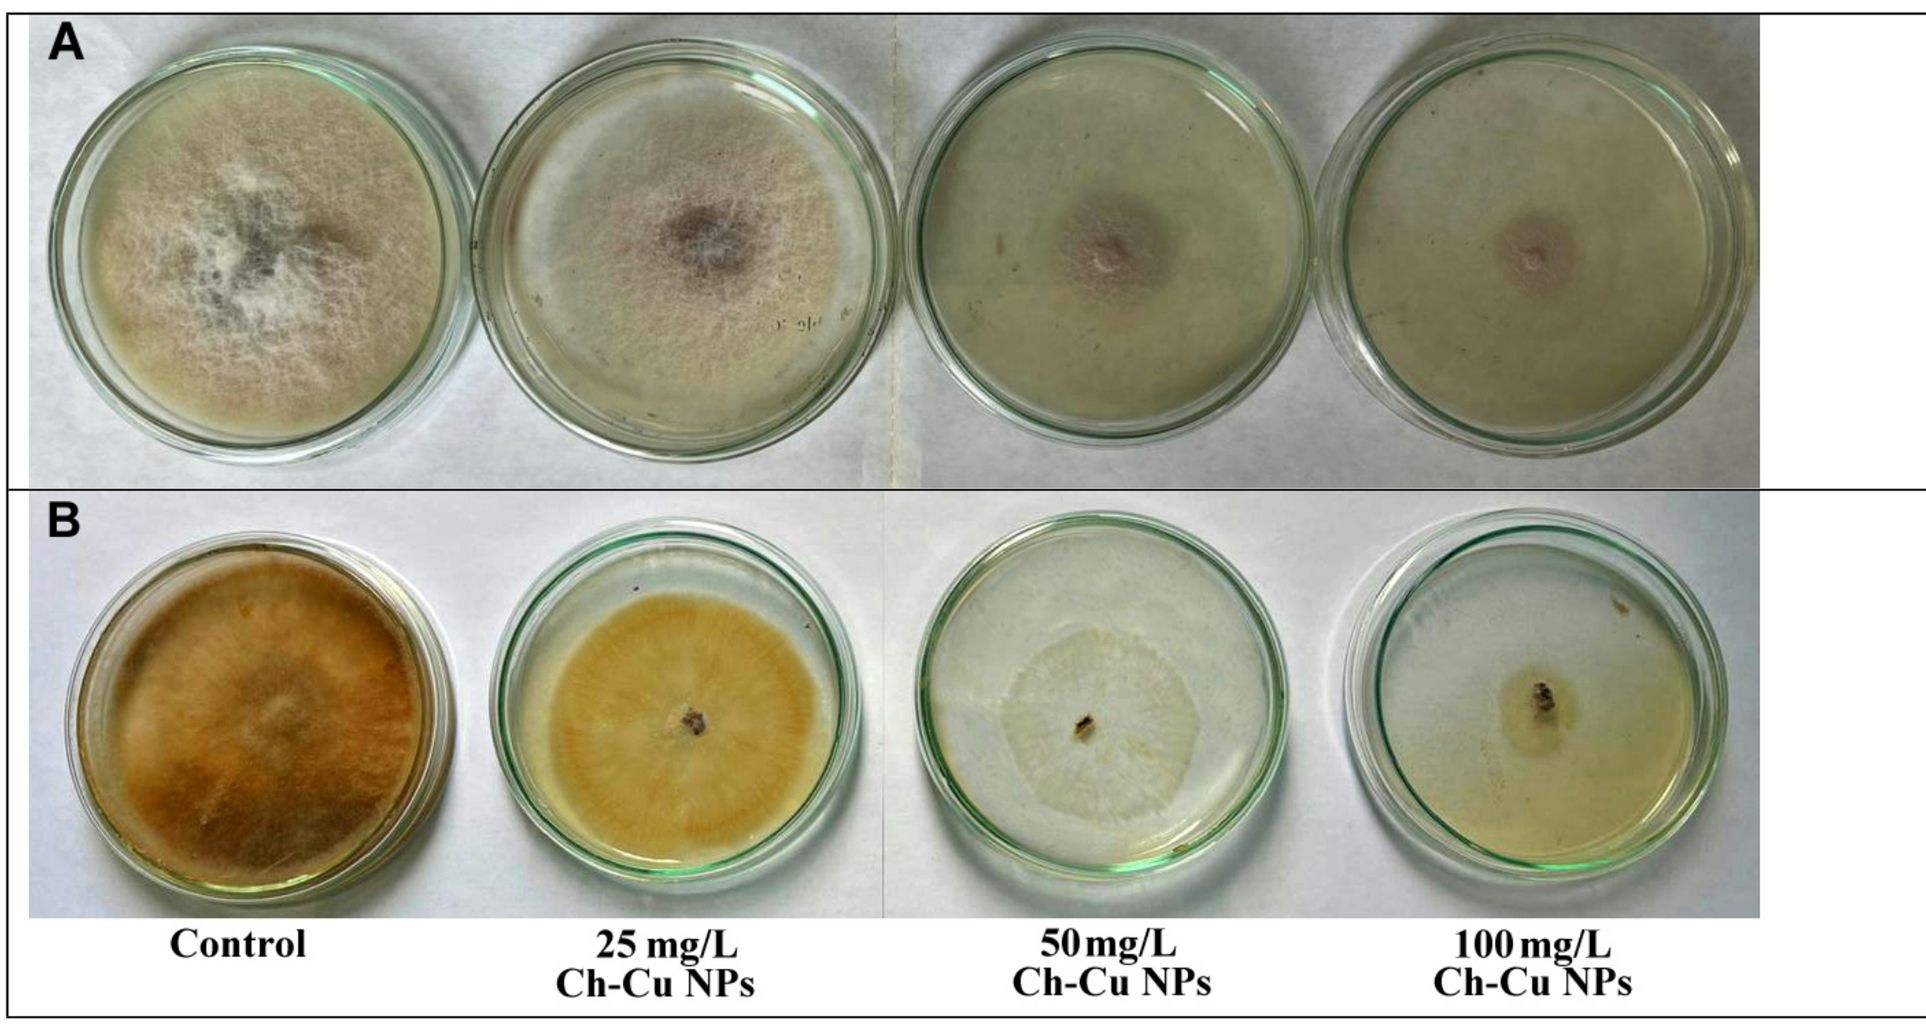
Fig. 5

Fig. 5

Effect of Ch-Cu NPs on the radial growth of F. oxysporum (A) and R. solani (B) with different concentration of Ch-Cu NPs.
Effect of Ch-Cu NPs on the radial growth of F. oxysporum (A) and R. solani (B) with different concentration of Ch-Cu NPs.